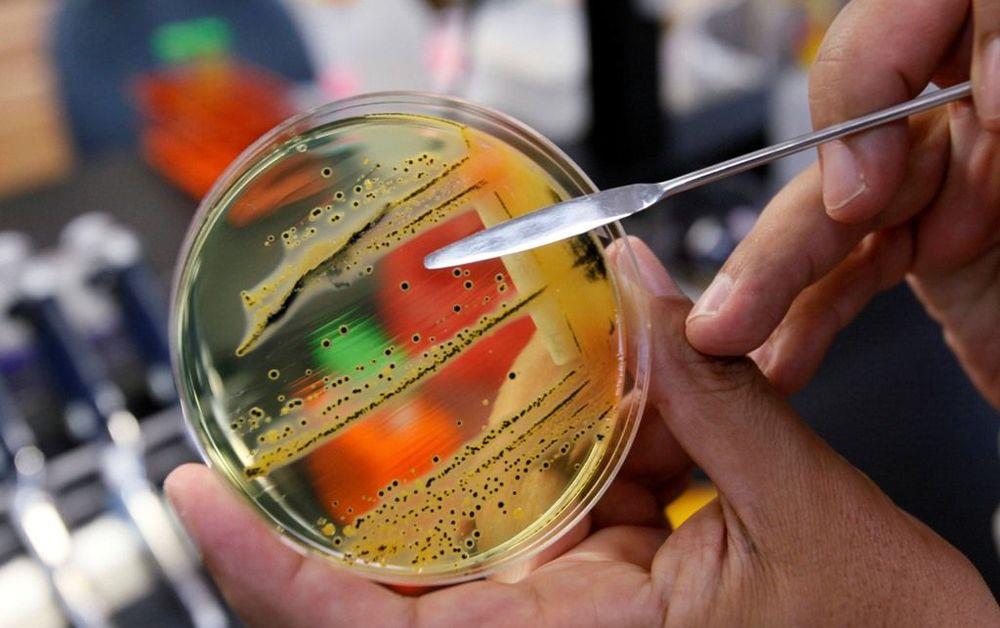

Επιδημία μηνιγγίτιδας απειλεί την Νιγηρία, ενώ έχουν καταγραφεί 745 θάνατοι, 250 περισσότερο σε μια μόλις εβδομάδα, σύμφωνα με ανακοίνωση των αρχών την Τετάρτη.
Σε όλη τη χώρα καταγράφηκαν πέραν των 8,000 περιστατικών τους τελευταίους 5 μήνες . Το μεγαλύτερο ποσοστό (πέρα του 93%) καταγράφεται σε πέντε βόρειες επαρχίες της χώρας.
Τα περισσότερα περιστατικά αφορούν παιδιά και οι αρχές εντείνουν τις εκστρατείες εμβολιασμών. Η μηνιγγίτιδα προκαλείται από διάφορα βακτήρια και μεταδίδεται με το φτάρνισμα και το βήχα. Αναπτύσσονται συμπτώματα πυρετού, πονοκεφάλων και δυσκαμψίας στον αυχένα.